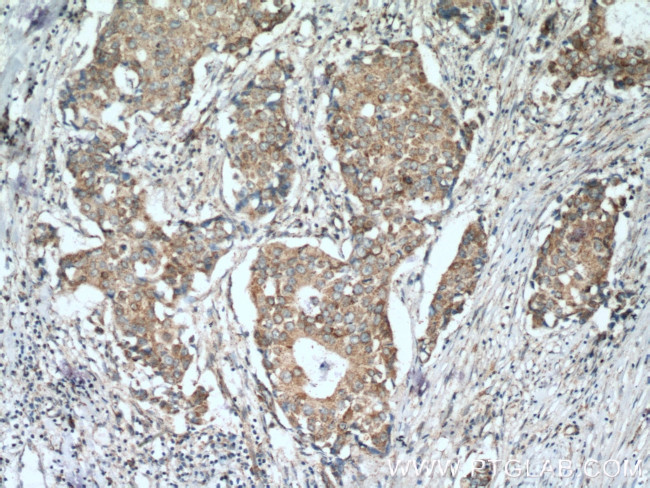
P5CS Antibody in Immunohistochemistry (Paraffin) (IHC (P))
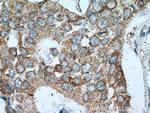
P5CS Antibody in Immunohistochemistry (Paraffin) (IHC (P))

Search
Proteintech
P5CS Polyclonal Antibody
{{$productOrderCtrl.translations['antibody.pdp.commerceCard.promotion.promotions']}}
{{$productOrderCtrl.translations['antibody.pdp.commerceCard.promotion.viewpromo']}}
{{$productOrderCtrl.translations['antibody.pdp.commerceCard.promotion.promocode']}}: {{promo.promoCode}} {{promo.promoTitle}} {{promo.promoDescription}}. {{$productOrderCtrl.translations['antibody.pdp.commerceCard.promotion.learnmore']}}
产品信息
17719-1-AP
种属反应
已发表种属
宿主/亚型
分类
类型
抗原
偶联物
形式
浓度
规格
纯化类型
保存液
内含物
保存条件
运输条件
产品详细信息
Immunogen sequence: MLSQVYRCG FQPFNQHLLP WVKCTTVFRS HCIQPSVIRH VRSWSNIPFI TVPLSRTHGK SFAHRSELKH AKRIVVKLGS AVVTRGDECG LALGRLASIV EQVSVLQNQG REMMLVTSGA VAFGKQRLRH EILLSQSVRQ ALHSGQNQLK EMAIPVLEAR ACAAAGQSGL MALYEAMFTQ YSICAAQILV TNLDFHDEQK RRNLNGTLHE LLRMNIVPIV NTNDAVVPPA EPNSDLQGVN VISVKDNDSL AARLAVEMKT DLLIVLSDVE GLFDSPPGSD DAKLIDIFYP GDQQSVTFGI KSRVGMGGME AKVKAALWAL QGGTSVVIAN GTHPKVSGHV ITDIVEGKKV GTFFSEVKPA GPT (1-362 aa encoded by BC106054)
靶标信息
This gene is a member of the aldehyde dehydrogenase family and encodes a bifunctional ATP- and NADPH-dependent mitochondrial enzyme with both gamma-glutamyl kinase and gamma-glutamyl phosphate reductase activities. The encoded protein catalyzes the reduction of glutamate to delta1-pyrroline-5-carboxylate, a critical step in the de novo biosynthesis of proline, ornithine and arginine. Mutations in this gene lead to hyperammonemia, hypoornithinemia, hypocitrullinemia, hypoargininemia and hypoprolinemia and may be associated with neurodegeneration, cataracts and connective tissue diseases. Alternatively spliced transcript variants, encoding different isoforms, have been described for this gene.
仅用于科研。不用于诊断过程。未经明确授权不得转售。
生物信息学
蛋白别名: Aldehyde dehydrogenase family 18 member A1; Delta-1-pyrroline-5-carboxylate synthase; delta-1-pyrroline-5-carboxylate synthetase; delta1-pyrroline-5-carboxlate synthetase; glutamate gamma-semialdehyde synthetase; MGC117316; P5CS; pyrroline-5-carboxylate synthetase (glutamate gamma-semialdehyde synthetase); spastic paraplegia 9 (autosomal dominant); Spastic paraplegia-9 (spastic paraparesis with amyotrophy, cataracts and gastroesophageal reflux); unnamed protein product
基因别名: 2810433K04Rik; ADCL3; AI429789; ALDH18A1; ARCL3A; GSAS; P5CS; PYCS; SPG9; SPG9A; SPG9B
UniProt ID: (Human) P54886, (Mouse) Q9Z110
Entrez Gene ID: (Human) 5832, (Rat) 361755, (Mouse) 56454